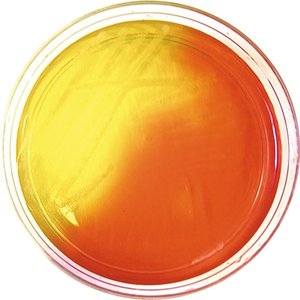
Phenol red pH indicator

BackBiochemistry Basics for Microbiology: Atoms, Molecules, and Macromolecules
Study Guide - Smart Notes
Tailored notes based on your materials, expanded with key definitions, examples, and context.
Biochemistry Basics
Atoms and Their Structure
Atoms are the fundamental units of matter, composed of a central nucleus containing protons and neutrons, surrounded by electrons in defined shells. The number of protons determines the atomic number and the identity of the element.
Protons: Positively charged particles in the nucleus.
Neutrons: Neutral particles in the nucleus.
Electrons: Negatively charged particles in electron shells.
Atomic mass: Sum of protons and neutrons.
Atomic number: Number of protons, unique for each element.

The Periodic Table
The periodic table organizes elements by increasing atomic number and groups elements with similar chemical properties. Each element is represented by a chemical symbol, atomic number, and atomic mass. 
Ions and Isotopes
Atoms can gain or lose electrons to form ions, or vary their number of neutrons to form isotopes.
Cations: Atoms that lose electrons, gaining a positive charge.
Anions: Atoms that gain electrons, acquiring a negative charge.
Isotopes: Atoms of the same element with different numbers of neutrons; important in medicine (e.g., radioactive tracers).

Molecules, Compounds, and Isomers
Molecules are formed when two or more atoms bond together. Compounds are molecules composed of different elements. Isomers have the same molecular formula but different structures.
Molecular formula: Shows the ratio of elements (e.g., H2O).
Isomers: Glucose, fructose, and galactose all share the formula C6H12O6 but differ structurally.

Organic vs. Inorganic Compounds
Organic compounds: Contain both carbon and hydrogen (e.g., C6H12O6).
Inorganic compounds: May contain carbon but lack associated hydrogen (e.g., CO2).
Functional Groups
Functional groups are specific groups of atoms within molecules that confer particular chemical properties and participate in chemical reactions. Key functional groups include:
Functional Group | Formula | Notes |
|---|---|---|
Amine | R-NH2 | Found in amino acids and nucleotides |
Carboxyl | R-COOH | Present in organic acids; ionizes to release H+ |
Ester | R-COO-R' | Formed by condensation of alcohol and acid; found in lipids |
Methyl | R-CH3 | Common in hydrocarbons; regulates gene expression |
Phosphate | R-PO42− | Found in DNA, RNA, ATP |

Acids, Bases, and Salts
Most cellular chemistry occurs in aqueous solutions. Acids release hydrogen ions (H+), bases release hydroxide ions (OH−), and salts form from acid-base reactions.
Solvent: Dissolving agent (usually water).
Solute: Substance dissolved in solvent.
Molarity: Concentration in mol/L.
Weight-volume proportion: Mass of solute per volume of solvent (e.g., mg/mL).

pH: A Measure of Acidity
The pH scale measures the concentration of H+ ions in a solution, ranging from 0 (acidic) to 14 (basic). Each unit change represents a tenfold change in H+ concentration.
Neutral: pH 7 (equal H+ and OH−).
Acidic: pH < 7 (more H+).
Basic: pH > 7 (more OH−).
Buffers: Compounds that stabilize pH by absorbing or releasing H+.
Chemical Bonds
Valence Electrons and Bonding
Valence electrons are those in the outermost shell and are involved in chemical bonding. Atoms with full valence shells are inert; those with incomplete shells are reactive.
Ionic Bonds
Ionic bonds form through the transfer of electrons between atoms, resulting in oppositely charged ions that attract each other. Dissolved ionic compounds release electrolytes, which are important for biological functions.

Covalent Bonds
Covalent bonds involve the sharing of electron pairs between atoms. Carbon, a key element in organic molecules, can form four covalent bonds and long chains (catenation).
Polar Covalent Bonds and Hydrogen Bonds
Polar covalent bonds result from unequal sharing of electrons, creating partial charges (dipoles). Hydrogen bonds are noncovalent attractions between molecules or within large molecules, crucial for the structure of water, proteins, and DNA.

Van der Waals Interactions
Temporary dipoles in molecules can lead to weak van der Waals interactions, which collectively stabilize molecular structures.
Hydrophobic, Hydrophilic, and Amphipathic Molecules
Hydrophilic: Water-loving, dissolve easily in water.
Hydrophobic: Water-fearing, do not dissolve in water.
Amphipathic: Contain both hydrophilic and hydrophobic regions (e.g., phospholipids, micelles).

Chemical Reactions
Types of Chemical Reactions
Chemical reactions involve the making and breaking of chemical bonds. Reactants are the starting materials, and products are the resulting substances.
Synthesis reactions: Combine reactants to form a product (A + B → AB).
Decomposition reactions: Break down compounds into simpler components (AB → A + B).
Exchange reactions: Swap components between compounds (A + BC → AC + B).

Energy in Chemical Reactions
Activation energy: Minimum energy required to start a reaction.
Catalysts: Substances that lower activation energy and speed up reactions.
Exergonic reactions: Release more energy than they consume; spontaneous.
Endergonic reactions: Consume more energy than they release; non-spontaneous.

Reversible Reactions and Equilibrium
Some reactions are reversible, reaching equilibrium when the forward and reverse rates are equal.
Biologically Important Macromolecules
The Four Main Classes of Biomolecules
Biomolecules are essential for life and include carbohydrates, lipids, nucleic acids, and proteins. Each class has unique building blocks and functions.
Biomolecule | Examples | Building Blocks | Notes |
|---|---|---|---|
Carbohydrates | Glucose, Sucrose, Glycogen | Simple sugars | Monosaccharides, disaccharides, polysaccharides |
Nucleic Acids | DNA, RNA | Nucleotides | Genetic material; DNA (deoxyribonucleotides), RNA (ribonucleotides) |
Proteins | Enzymes, Antibodies | Amino acids | Catalysts, immune response |
Lipids | Fats, Oils, Waxes, Steroids | Glycerol, fatty acids | Energy storage, cell membranes |
Carbohydrates
Carbohydrates are organic molecules made of carbon, hydrogen, and oxygen, typically following the formula (CH2O)n. They serve as energy sources, structural components, and in cell communication.
Monosaccharides: Single sugar units (e.g., glucose, fructose, galactose).
Disaccharides: Two monosaccharides linked by glycosidic bonds (e.g., sucrose).
Polysaccharides: Long chains of monosaccharides (e.g., glycogen, cellulose, chitin).

Lipids
Lipids are hydrophobic organic molecules, including fats, oils, waxes, and steroids. They are important for energy storage, cell structure, and signaling.
Saturated lipids: No double bonds; solid at room temperature (e.g., butter).
Unsaturated lipids: One or more double bonds; liquid at room temperature (e.g., olive oil).
Triglycerides: Glycerol + three fatty acids.
Phospholipids: Amphipathic; form cell membranes.

Nucleic Acids
Nucleic acids (DNA and RNA) are polymers of nucleotides, which consist of a five-carbon sugar, phosphate group(s), and a nitrogenous base. DNA is double-stranded; RNA is single-stranded.
Phosphodiester bonds: Link nucleotides, forming the sugar-phosphate backbone.
ATP: A ribonucleotide that stores and releases energy for cellular processes.
Proteins
Proteins are polymers of amino acids, each with an amine group, carboxyl group, and a variable side chain (R group). Protein structure is organized into four levels:
Primary: Linear sequence of amino acids.
Secondary: Alpha-helices and beta-pleated sheets.
Tertiary: 3D folding due to interactions between side chains.
Quaternary: Association of multiple polypeptide chains.
Functions: Structural support, enzymes, transport, cell recognition, and communication. Additional info: Chaperone proteins assist in proper protein folding, preventing misfolding and aggregation.